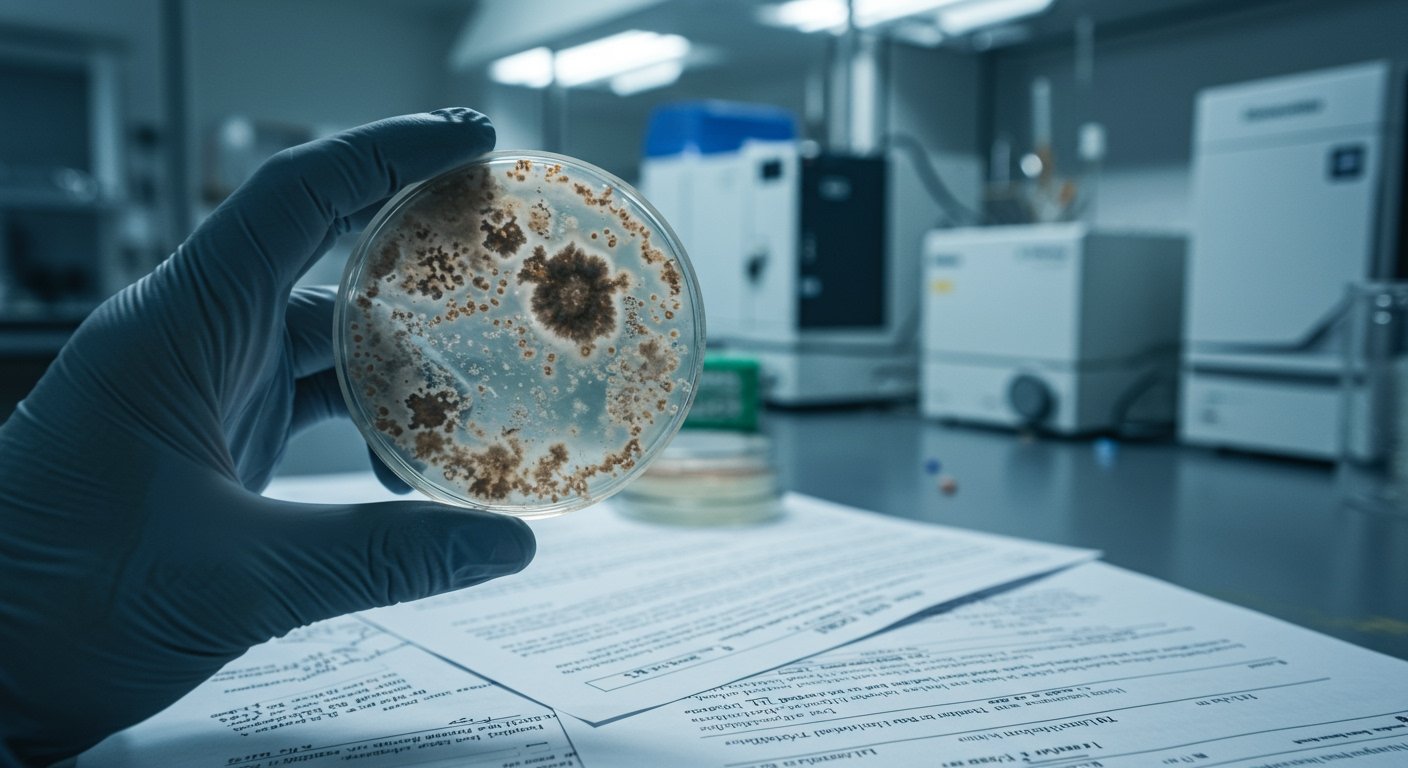

A recent report has cast a critical light on the oversight – or lack thereof – within the burgeoning state-legal cannabis markets and the federal approach to cannabis research. Central to the allegations is the performance of the Drug Enforcement Administration (DEA), and specifically its Deputy Administrator Thomas Prevoznik, who heads the agency’s Diversion Control Division.
The report, highlighted by ACCESS Newswire, alleges a dual failure by the DEA: permitting contaminated cannabis products to reach consumers in state markets, potentially leading to poisoning, while simultaneously hindering the progress of legitimate pharmaceutical cannabis research. [13]
Market Safety Concerns
The core of the market safety critique revolves around inadequate national oversight and quality control within state-run cannabis programs. The report points to regulatory failures at the state level as a direct consequence of this federal vacuum.
A striking example cited is the situation in Massachusetts. State regulators there were compelled to suspend the license of Assured Testing Laboratories, one of the largest cannabis testing facilities in the state. Assured Testing Laboratories was reportedly responsible for testing approximately 25% of Massachusetts’ cannabis supply. [13]
The accusations against Assured Testing Laboratories are severe. They include allegations of intentionally concealing failing safety test results, falsifying reports, and actively hiding evidence of contamination. This contamination reportedly included issues related to yeast, mold, and various microbial contaminants. By approving products that should have failed mandatory state safety standards, the lab is alleged to have allowed thousands of untested or improperly tested products to reach consumers. [13]
The report asserts that the DEA’s alleged inaction or policy choices have contributed to this environment where potentially dangerous products can enter the supply chain without sufficient checks and balances at a federal level, despite the DEA’s role in drug control and diversion prevention.
Impediments to Pharmaceutical Research
Beyond market safety, the report also addresses the DEA’s stance on cannabis research, particularly concerning its pharmaceutical potential. The allegations contend that the DEA has been actively blocking the development of federally compliant pharmaceutical cannabis.
A specific instance highlighted involves MMJ BioPharma. This organization is noted for conducting FDA-approved clinical research into the therapeutic uses of cannabis for serious neurological conditions. The report specifically mentions MMJ BioPharma’s research efforts targeting debilitating diseases such as Huntington’s Disease and Multiple Sclerosis. [13]
According to the report’s claims, the DEA’s actions are creating significant hurdles for such critical research, preventing potential medical advancements and access to new treatments for patients suffering from these conditions, even when the research protocols have received approval from the Food and Drug Administration (FDA), the primary federal body for evaluating drug safety and efficacy.
Calls for Accountability
The allegations presented in the report raise significant questions about the effectiveness of current federal oversight regarding cannabis, even in states where it is legal under state law. Critics argue that the current approach leaves consumers vulnerable to unsafe products while stifling potentially life-changing medical research.
The focus on Deputy Administrator Thomas Prevoznik, who leads the division responsible for preventing diversion of controlled substances, underscores the report’s implication that leadership at the DEA plays a direct role in these alleged failures. [13]
As state cannabis markets continue to mature and expand across the United States, and as the scientific community seeks to further explore the medicinal properties of cannabis, the report’s allegations present a complex challenge for federal agencies tasked with drug control and public health.
Addressing the concerns raised may require a re-evaluation of federal policy and enforcement strategies to ensure both consumer safety within state markets and the unimpeded progress of rigorous, federally approved scientific research into cannabis-based medicines.